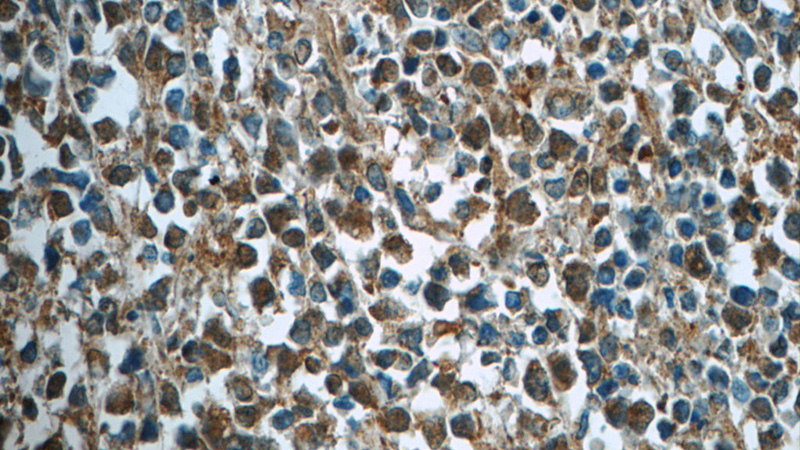
Immunohistochemistry of paraffin-embedded human lymphoma tissue slide using Catalog No:107147(CDK2 Antibody) at dilution of 1:50 (under 40x lens)

-
Product Name
CDK2 antibody
- Documents
-
Description
CDK2 Mouse Monoclonal antibody. Positive FC detected in Jurkat cells. Positive IHC detected in human lymphoma tissue, human cervical cancer tissue. Positive WB detected in K-562 cells. Observed molecular weight by Western-blot: 37 kDa
-
Tested applications
ELISA, IHC, WB, FC
-
Species reactivity
Human; other species not tested.
-
Alternative names
CDK2 antibody; Cell division protein kinase 2 antibody; cyclin dependent kinase 2 antibody; p33 protein kinase antibody; p33(CDK2) antibody
-
Isotype
Mouse IgM
-
Preparation
This antibody was obtained by immunization of CDK2 recombinant protein (Accession Number: NM_001798). Purification method: Caprylic acid/ammonium sulfate precipitation.
-
Clonality
Monoclonal
-
Formulation
PBS with 0.02% sodium azide and 50% glycerol pH 7.3.
-
Storage instructions
Store at -20℃. DO NOT ALIQUOT
-
Applications
Recommended Dilution:
WB: 1:500-1:5000
IHC: 1:20-1:200
-
Validations

K-562 cells were subjected to SDS PAGE followed by western blot with Catalog No:107147(CDK2 Antibody) at dilution of 1:1000

Immunohistochemistry of paraffin-embedded human lymphoma tissue slide using Catalog No:107147(CDK2 Antibody) at dilution of 1:50 (under 10x lens)
Immunohistochemistry of paraffin-embedded human lymphoma tissue slide using Catalog No:107147(CDK2 Antibody) at dilution of 1:50 (under 40x lens)

1X10^6 Jurkat cells were stained with 0.2ug CDK2 antibody (Catalog No:107147, red) and control antibody (blue). Fixed with 90% MeOH blocked with 3% BSA (30 min). Alexa Fluor 488-congugated AffiniPure Goat Anti-Mouse IgG(H+L) with dilution 1:1000.
-
Background
CDK2(Cyclin-dependent kinase 2) is also named as CDKN2 and belongs to the protein kinase superfamily,CMGC Ser/Thr protein kinase family, CDC2/CDKX subfamily.It is involved in the control of the cell cycle; essential for meiosis, but dispensable for mitosis.It has 2 isoforms produced by alternative splicing.
-
References
- Meng D, Chen Y, Yun D. High expression of N-myc (and STAT) interactor predicts poor prognosis and promotes tumor growth in human glioblastoma. Oncotarget. 6(7):4901-19. 2015.
Related Products / Services
Please note: All products are "FOR RESEARCH USE ONLY AND ARE NOT INTENDED FOR DIAGNOSTIC OR THERAPEUTIC USE"
